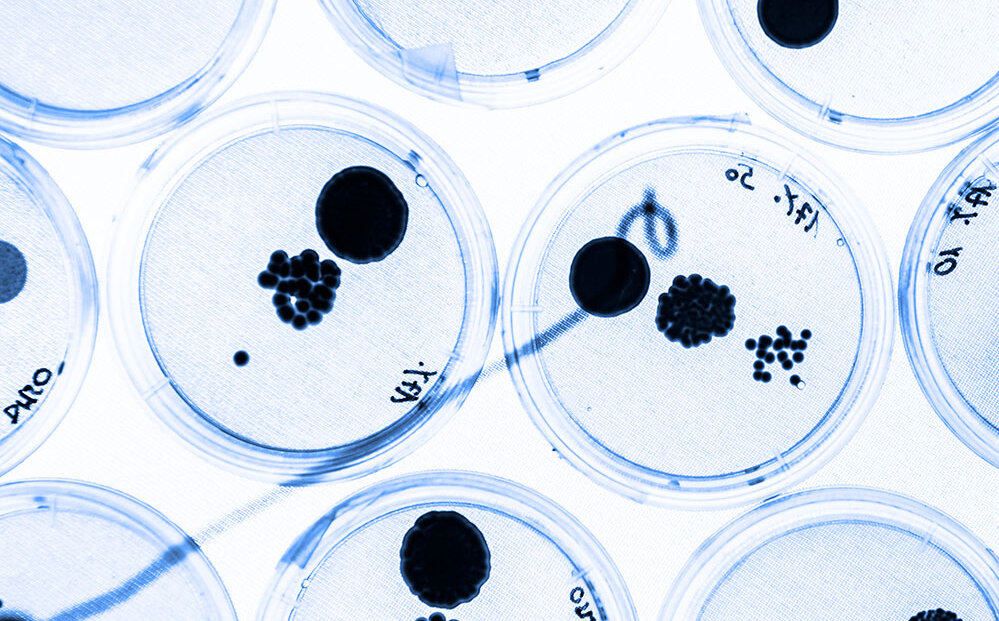

Les antibiotiques doivent être mis en œuvre avec le plus grand soin et de manière autant que possible ciblée. La médecine vétérinaire collabore depuis plusieurs années dans le cadre de la Stratégie nationale d’antibiorésistance (StAR) et met en œuvre des mesures concrètes. En font partie, outre la promotion du suivi de troupeau, l’élaboration et l’application de directives thérapeutiques comme de programmes sanitaires préventifs ainsi que l’introduction de stratégies vaccinales.
Mesures mises en œuvre par les vétérinaires pour parer à l’antibiorésistance